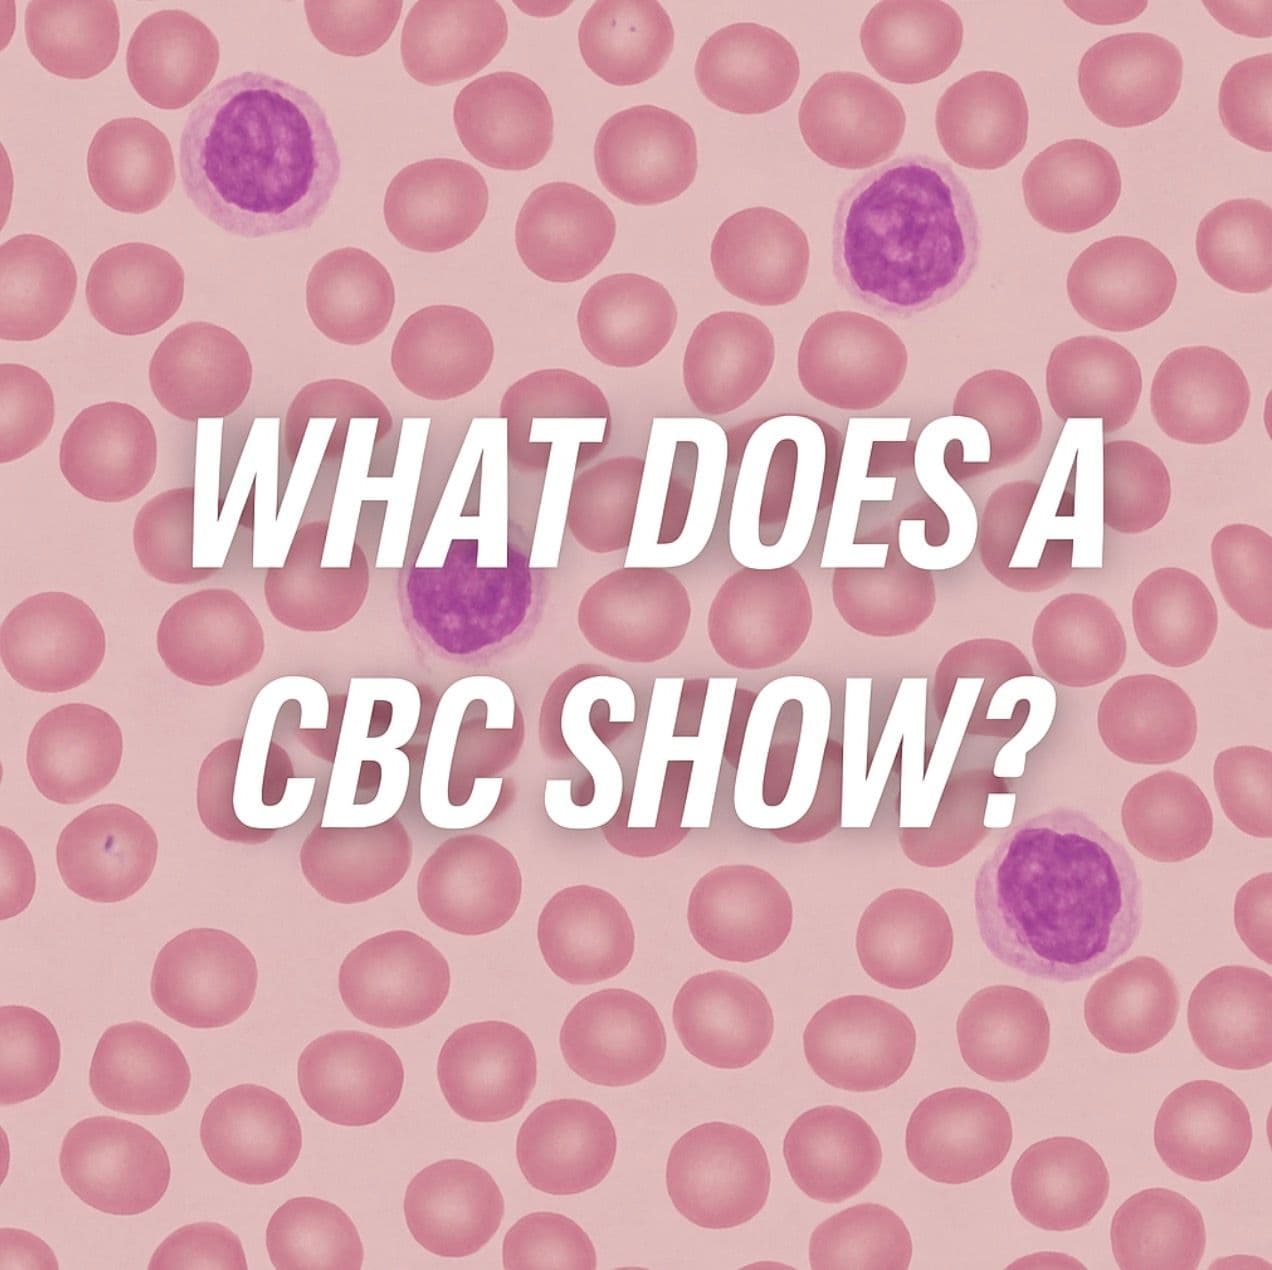
What Does a CBC Show? A Complete Guide to the Test and Its Importance

Published on:
Updated on:
He did misspeak, thank you for pointing that out. Yes, DRUG concentrations were >100 less with the topical vs the oral version of finasteride. As always, our YouTube channel is an informal venue, and ... See Full Answer
There are zero studies to cite where enclomiphene is used concurrently with TRT. For this reason, its use is still considered experimental. We have seen some men still maintain a measurable LH level ... See Full Answer
For us, we have had a significant number of patients join us with slight anxiety or depression start TRT and find that those mental health issues improved or went away for them. It is likely that it w... See Full Answer
At AlphaMD, we're here to help. Feel free to ask us any question you would like about TRT, medical weightloss, ED, or other topics related to men's health. Or take a moment to browse through our past questions.
When it comes to understanding your health, blood tests are one of the most valuable diagnostic tools available. Among them, the Complete Blood Count (CBC) is one of the most commonly ordered by physicians. But what does a CBC show, and why is it so important? This guide will break down what the test measures, what doctors look for in the results, and how it connects to broader health issues.
For patients undergoing testosterone replacement therapy, CBC testing is often used to monitor how treatment may be affecting red blood cell counts and overall blood health. Understanding what this test reveals can help patients take a more active role in managing their care.
A CBC is a blood test that evaluates the three main types of cells circulating in your blood:
In addition, a CBC provides key measurements such as hematocrit, hemoglobin, and mean corpuscular volume (MCV), which give insight into oxygen-carrying capacity and red cell health.
A CBC is not just a routine formality—it helps uncover a wide range of health conditions, including:
Doctors often use CBC results in combination with patient history, symptoms, and other lab work to arrive at a diagnosis or monitor ongoing treatment.
Patients receiving hormone therapies such as TRT may require periodic CBC tests. Testosterone can stimulate red blood cell production, which is beneficial in correcting anemia but must be monitored carefully to avoid elevated levels that increase cardiovascular risk. Regular CBC testing ensures treatment is both safe and effective.
If your doctor orders a CBC, it usually involves a simple blood draw with results available in a day or two. Most minor abnormalities are not cause for alarm, but significant changes—especially when paired with symptoms—warrant further evaluation.
What does a CBC show about overall health?
It provides a snapshot of your blood health, detecting anemia, infections, immune issues, and blood clotting abnormalities.
Is fasting required for a CBC?
No, fasting is not typically necessary for a CBC alone, though it may be combined with other tests that require fasting.
How often should CBC testing be done during testosterone replacement therapy?
Frequency depends on individual treatment plans, but many providers recommend checking every 3–6 months, especially early in therapy.
Can lifestyle affect CBC results?
Yes. Hydration, altitude, smoking, and medications can all influence red blood cell counts and other values.
Understanding what a CBC shows empowers patients to be active participants in their healthcare. This simple test reveals critical insights about red and white blood cells, platelets, and overall blood function. For individuals undergoing treatments like testosterone replacement therapy, it is an essential safety measure. At AlphaMD, we prioritize patient education and ongoing monitoring to ensure treatments are safe, effective, and tailored to each person’s health needs.
At AlphaMD, we're here to help. Feel free to ask us any question you would like about TRT, medical weightloss, ED, or other topics related to men's health. Or take a moment to browse through our past questions.
He did misspeak, thank you for pointing that out. Yes, DRUG concentrations were >100 less with the topical vs the oral version of finasteride. As always, our YouTube channel is an informal venue, and ... See Full Answer
There are zero studies to cite where enclomiphene is used concurrently with TRT. For this reason, its use is still considered experimental. We have seen some men still maintain a measurable LH level ... See Full Answer
For us, we have had a significant number of patients join us with slight anxiety or depression start TRT and find that those mental health issues improved or went away for them. It is likely that it w... See Full Answer
Enter your email address now to receive $30 off your first month’s cost, other discounts, and additional information about TRT.
This website is a repository of publicly available information and is not intended to form a physician-patient relationship with any individual. The content of this website is for informational purposes only. The information presented on this website is not intended to take the place of your personal physician's advice and is not intended to diagnose, treat, cure, or prevent any disease. Discuss this information with your own physician or healthcare provider to determine what is right for you. All information is intended for your general knowledge only and is not a substitute for medical advice or treatment for specific medical conditions. The information contained herein is presented in summary form only and intended to provide broad consumer understanding and knowledge. The information should not be considered complete and should not be used in place of a visit, phone or telemedicine call, consultation or advice of your physician or other healthcare provider. Only a qualified physician in your state can determine if you qualify for and should undertake treatment.